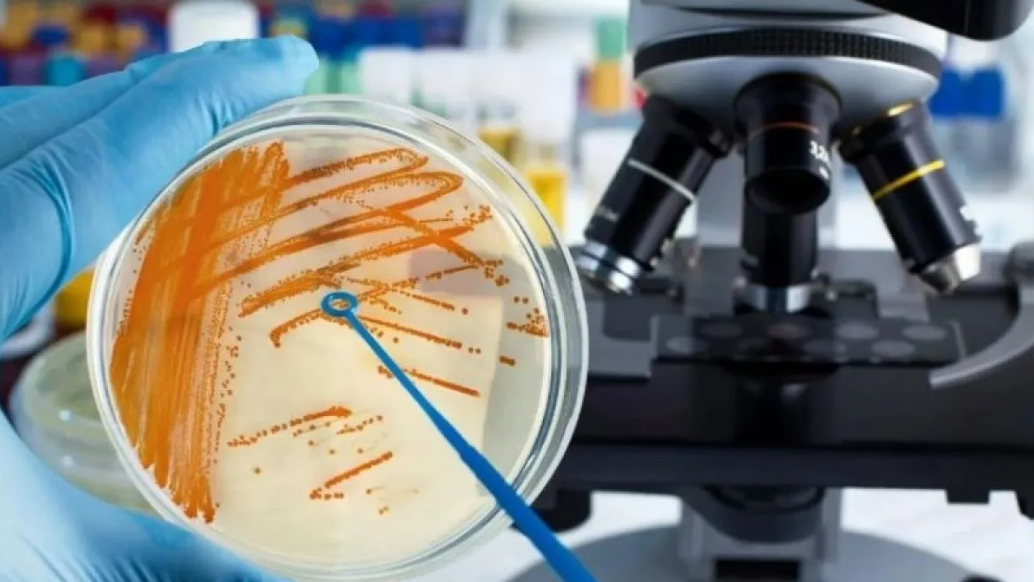
Sin título

Aguas Blancas: Más de 2000 personas fueron retiradas del padrón tras los controles
El juez Julio Bavio había ordenado controlar los padrones electorales en Aguas Blancas tras las denuncias por irregularidades.
Se trata de Streptococcus Pyogenes, una bacteria muy agresiva, sobre todo en niños, que puede nacer como faringitis o hasta infecciones cutáneas.
Salta07 de noviembre de 2023
FR prensa 4
Mientras precisaba los detalles de la compra de más de 300 mil vacunas para mitigar los efectos del dengue en Salta, el ministro de Salud Federico Mangione confirmó que ua son tres los fallecidos en la provincia por el avance de la bacteria Streptococcus Pyogenes.
Según datos oficiales de Nación, en el país ya son 78 los fallecidos y hay 487 casos confirmados.
Mangione confirmó que hasta fines de octubre se habían registrado dos muertes y al menos siete casos positivos con la bacteria.
No obstante, el ministro de Salud pidió tranquilidad a los salteños ya que se trabaja en el asunto y hay un monitoreo permanente.
Vale recordar que el Streptococcus del grupo A, como también se lo llama, es una bacteria Gram-positiva y es la causa bacteriana más frecuente de faringitis aguda e infecciones cutáneas como impétigo, celulitis y escarlatina.

El juez Julio Bavio había ordenado controlar los padrones electorales en Aguas Blancas tras las denuncias por irregularidades.

La gira se extenderá durante tres días y se contemplan visitas en las ciudades de Hyderabad, Mumbai y Nueva Delhi

Se ofrecerá productos, gastronomía, espectáculos y servicios municipales

Se ofrecerá productos, gastronomía, espectáculos y servicios municipales

El cálculo de recursos supera los $69 mil millones y se aprobó antes de fin de año, un hecho inédito en 40 años. El plan prioriza becas, bienestar estudiantil, investigación y fortalecimiento académico.

La empresa ajustó recorridos de varios corredores debido a trabajos viales en la zona. Piden prever demoras y consultar los nuevos trayectos hasta que finalicen las obras.

La Cámara Federal rechazó el intento del exdiputado de apartar a la magistrada salteña. Con el fallo, la causa por peculado, abuso de autoridad e intimidación pública retoma su curso.

Tras pasar diez años preso por un crimen que no cometió, el baqueano salteño reconstruye su historia marcada por pérdidas, encierro y resiliencia. Hoy, sobreseído, dedica su vida a su familia y al cuidado de su hija con parálisis cerebral.

El Gobierno provincial confirmó tres nombramientos clave y dejó descartado un cuarto recambio ministerial. Quedan dos secretarías pendientes de designación.

La Casa Rosada sumó al proyecto el artículo 91, que ordena el traspaso de los juzgados laborales a la Ciudad de Buenos Aires y anticipa la disolución del fuero nacional. La medida reaviva tensiones con jueces, sindicatos y sectores opositores.

Se llevará a cabo el 13 y 14 de diciembre, de 11 a 00 hs.

Los ataques comenzaron cuando la víctima tenía 10 y se extendieron durante siete. La mujer por ahora permanece en libertad, ya que el fallo no está firme.

Nuevas informaciones aportan más contexto sobre la reciente comunicación entre Nicolás Maduro y el presidente estadounidense Donald Trump.

El 12 de diciembre es una fecha de festejo para la hichada “Xeneize”, una tradición que surgió hace casi cien años.

La Justicia encontró autos importados, motos de alta cilindrada y una Ferrari en un galpón de la finca de Villa Rosa, propiedad de Real Central SRL. El caso avanza con nuevos allanamientos y el levantamiento del secreto fiscal.

El teniente general Carlos Alberto Presti juró ante el Presidente y presentó un equipo integrado por oficiales en actividad y retirados. Su primera prioridad será intervenir IOSFA para ordenar la obra social de las Fuerzas Armadas y de Seguridad.

La cepa K de influenza A provoca un brote anticipado y severo en Europa y podría llegar a Sudamérica durante el otoño austral. Epidemiólogos insisten en que adultos mayores, niños pequeños, embarazadas y pacientes crónicos se vacunen a tiempo.

La Cámara Federal rechazó el intento del exdiputado de apartar a la magistrada salteña. Con el fallo, la causa por peculado, abuso de autoridad e intimidación pública retoma su curso.

La empresa ajustó recorridos de varios corredores debido a trabajos viales en la zona. Piden prever demoras y consultar los nuevos trayectos hasta que finalicen las obras.